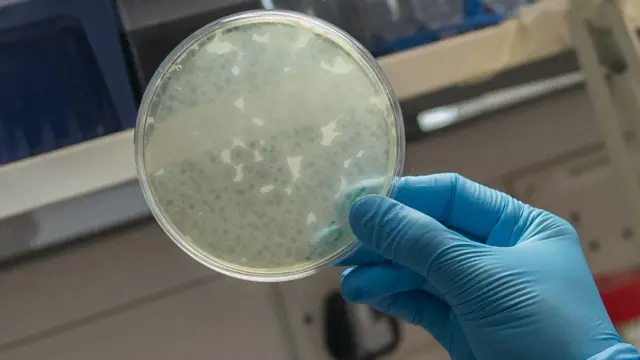
Close up of a petri dish held in a blue gloved hand

Ҳожатхонадаги бактерия инсонлар ҳаётини асраб қолиши мумкин

- Author, Жеймс Галлаҳер
- Role, Би-би-сининг саломатлик ва илм-фан мухбири
- Ўқилиш вақти: 6 дақ
Мен инфекцияларни даволаши мумкин бўлган халоскор вирусни қидиряпман.
Биз барчамиз вирус "ёмон болалар"ни яхши биламиз – ковид, грипп, норовирус, герпес, сувчечак, қизамиқ… рўйхат тугамайди.
Бироқ шундай вирус борки, у инсон организмига эмас, балки бактерияларга ҳужум қилади.
Улар бактерияхўрлар, «бактериофаглар» ёки шунчаки «фаглар» деб аталади.
Бундай вирусларни топсак, антибиотикларга дош бераётган хавфли "супербактериялар"дан даволанишнинг янги усулини очиш мумкин.
Хўш, бундай "қотил" вирусни қандай тутамиз?
Айтишларича, бу ажабланарли даражада осон экан. Phage Collection Project жамоаси менга намуна тўплаш учун флаконлар ва қўлқоп юборди. Мендан талаб қилинадиган иш – шунчаки ифлос сув топиб, флаконни ботириш ва қопқоғини ёпиш.

Мен бир неча ҳавзалардан, қурт-компост идишидан намуна олдим. Энди эса энг ифлос манба керак эди. Шу боис, ҳожатхонадаги "катта ҳожат"дан сўнг сувини бир неча соат тортмасдан қолдирдим. Қўлқоп кийиб, нафасни ушлаб, сўнг намуна олдим. Барча гигиена қоидаларига – айниқса, қўлларни астойдил ювишга қатъий амал қилдим.
Флаконлар лабораторияга юборилди. Уч кундан сўнг мен Саутгемптон университетига йўл олдим – натижаларни кўриш учун.
"Олганимда улар анча ифлос эди," дейди фаглар бўйича олим Мишел Лин, биз микроорганизмлар устида ишлашга мўлжалланган 2-даражали хавфсизлик лабораториясига кириш арафасида кўк халат ва махсус қўлқоп кийдик.
Музлаткичдан менинг флаконларимни чиқариб олдик – улар эндиликда анча тоза, ифлосликлардан фильтрланганди.
"Ҳаммаси жойида – бу жараён учун зарур," дейди Мишел, бу ёқимсиз ишни бажарган инсон.

Фильтрлаш – фагларни топишдаги биринчи босқич. Кейин уларга "таом" – фаглар яхши кўрадиган бактериялар аралашмаси – берилади, кўпайишлари учун.
Энди эса энг қизиқ қисм – фойдали фагни топиш. Олимлар яқин атрофдаги шифохонадан даволаш мушкул бўлган инфекцияларга чалинган беморлардан бактерия намунасини тўплашган.
Мишел менга Петри идишини кўрсатади – унда қайта-қайта сийдик йўллари инфекциясига сабаб бўладиган бактериялар ўсмоқда.
Мен учун ҳақиқий ҳайрат – ҳожатхонадан олган фагларимдан бири ушбу инфекцияни лаборатория шароитида йўқ қила олгани.
"Фаг бактерияни зарарлаганини шундай кўрасиз: бактерия ўсмаган жойларда ҳалқасимон тешикчалар пайдо бўлади – улар фаглар тозалаган жойлар," деб тушунтиради Мишел.
Идишда леопард терисига ўхшаш нақшлар пайдо бўлган – фаглар замонавий тиббиёт ечим топа олмаган инфекцияни осон йўқ қилганди.
"Қанча ғалати туюлмасин, ҳожатхона намунасига раҳмат," дейди Мишел, табассум билан.
Фагга ном қўйиш имконияти берилганда, мен унга Галлахер-фаг деб ном қўйдим.
"Менга ажойиб эшитиляпти бу ном," деди Мишел мамнуният билан.
Ҳозирча бунинг ҳаммаси лабораториядаги қизиқарли тажриба, лекин фагим бир кун келиб ҳақиқатан беморни даволаш учун қўлланиши мумкинми?
"Ҳа, мен шунга умид қиламан," дейди Саутгемптон университетининг ассистент профессори доктор Франклин Нобрега, фагимнинг электрон микроскопдаги тасвирини кўрсатар экан.
"Сизнинг фагингиз атиги 24 соат ичида юқори концентрацияга эришди ва кучли бактерия қотилига айланди. Демак, бу беморлар учун умидбахш натижа. Раҳмат сизга," дея таъкидлайди доктор Нобрега.

Фаглар менга Ойга қўнадиган капсулани эслатади – катта тана ва ингичка оёқчалар. Лекин улар Ойга тушиш ўрнига, шу оёқлар орқали қурбонларини танлайди.
Фаг бактерия ичига кириб олиб, уни ўзининг кўпайиш фабрикасига айлантиради. Сўнг янги фаглар бактерия ичидан ёриб чиқиб, уни йўқ қилади.
Фагларнинг ўз афзаллик ва камчиликлари бор. Улар организм ичида кўпайиши мумкин, шунинг учун антибиотиклардек доимий дозалар керак бўлмайди.
Лекин улар жуда танловчан: ҳар бир бактерия штаммига мос фаг керак бўлади. Антибиотиклар эса, аксинча, яхши ва ёмон бактерияларни фарқламай, ҳаммасини йўқ қилади. Шунинг учун тўғри фагни топиш мушкулроқ, бироқ топилса – нохуш таъсирлари анча кам.
Доктор Нобрега менга айтишича, фагларни ярали жароҳатларда қўллаш жуда қулай, чунки уларни тўғридан-тўғри ярага суртиш мумкин. Шунингдек, ингалятор орқали нафас йўллари инфекцияларини даволаш ёки сийдик йўллари инфекцияларига қарши ҳам қўллаш мумкин.
"Айни пайтда биз айнан шуни тадқиқ қилмоқдамиз," дейди у.

Сурат манбаси, Getty Images
Фаг – дўст вирус
Фаг илми янги ва ҳайратланарли туюлиши мумкин, аммо аслида у 1910-йилларда Феликс д'Эрел ва Фредерик Туорт қилган кашфиётларга бориб тақаладиган юз йиллик ғоядир.
Бактериофаг терапияси тиббиётнинг бир бўлими сифатида шаклланган ва ўз вақтида жуда жозибадор ғоя бўлган. Ҳатто 1940-йилларга келиб ҳам Ғарб мамлакатларида бактериал инфекцияларга қарши курашиш учун фаг терапиясини ишлаб чиқаришга уринаётган фаол фармацевтика саноати мавжуд эди.
Бироқ бу усул 20-асрнинг мўъжизавий дориси – антибиотиклар соясида қолди.

Сурат манбаси, University of Southampton
«Антибиотиклар жуда яхши иш бераётган эди, шунинг учун одамлар: "Бўлди-да, бошқа нима керак?" дейишарди», дейди доктор Нобрега.
Фаг терапияси бўйича ишлар Жоржия каби жойларда давом этган ва унинг ажойиб самаралари ҳақида алоҳида ҳикоялар бор. Аммо антибиотиклар каби бу усул бўйича етарли тиббий тадқиқотлар ва клиник синовлар ўтказилмаган.
Бир вақтлар антибиотикларнинг дастлабки муваффақияти фаг илмини тўхтатган бўлса, ҳозир эса антибиотиклар самарасизлиги бу илмий соҳани яна жонлантирмоқда.

Сурат манбаси, .
Ҳар йили дунёда бир миллиондан ортиқ киши даволаб бўлмас бактериялар туфайли юзага келган инфекциядан вафот этмоқда – бу ҳолат «сассиз пандемия» деб аталади. 2050-йилга бориб, бу кўрсаткич йилига 10 миллион кишига етиши мумкин.
Бу «антибиотик апокалипсиси» шундай ҳолга олиб келадики, оддий инфекциялар яна ўлимга сабаб бўлиши ва замонавий тиббиёт пойдеворини издан чиқариши мумкин. Чунки антибиотиклар ишламаса, орган трансплантацияси, очиқ жарроҳлик ва кимётерапия имкони йўққа чиқиши мумкин.
«Антибиотикларга чидамлилик ҳақидаги башоратлар жуда даҳшатли, аммо аслида биз буни аллақачон кўряпмиз ва бу фақат ёмонлашиб боради», дейди Саутгемптон университети қошидаги Тиббий инновациялар институти директори, профессор Пол Элкингтон.

У ўпка касалликлари бўйича мутахассис шифокор ҳамдир ва айтишича, бир йиллик даводан сўнг, бора-бора заҳарли ва кам самарали антибиотикларга ўтилади ва охири бемор билан шундай суҳбат бўлади: «Кечиринг, бу инфекцияни даволай олмаймиз».
Унинг айтишича, келажакда биз фақат антибиотикларга суяна олмаймиз ва фаглар муқобил усул ҳисобланади.
Бироқ у лабораториядан беморгача бўлган йўл «номаълум» эканини ҳам таъкидлайди.
Шу билан бирга, вазият ўзгармоқда. Буюк Британияда фаг терапияси бошқа муолажалар самарасиз бўлганда қўлланиши мумкин. Мамлакат дори воситалари назорати органи – Дори ва тиббиёт маҳсулотлари агентлиги фаг терапиясини ривожлантиришни қўллаб-қувватлаш мақсадида илк расмий қоидаларини эълон қилди.
«Агар келаси 15–20 йилга назар ташласак, ривожланаётган методлар туфайли фаглар анча оммавий ва кенг қўлланадиган бўлиши, ҳатто айрим инфекцияларда шифокорлар антибиотик ўрнига фаг тайинлаши мумкин бўлади», дейди профессор Элкингтон.
Агар сиз ҳам фойдали вирусни топа оласизми, деб қизиқсангиз, The Phage Collection Project шу ҳафта Британия Қироллик жамиятида ўтаётган Ёзги илм-фан кўргазмаси ва ўз веб-сайти орқали янги намуналар олиш тўпламларини тақдим этмоқда.
«Антибиотикка қаршилик ҳар биримизнинг ҳаётимизга таъсир қилиши мумкин, – дейди Phage Collection Project вакиласи Эсми Бринсден. – Агар жамоатчилик бу ишда иштирок этса, улар беморни даволаш ва ҳаётини сақлаб қолишга ёрдам берадиган навбатдаги фагни топишлари мумкин».
Фотоларни Би-би-си мухбири Эмма Линч олган












